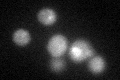
YNL126W

View description
Component of the microtubule-nucleating Tub4p (gamma-tubulin) complex; interacts with Spc110p at the spindle pole body (SPB) inner plaque and with Spc72p at the SPB outer plaque
Localization:
Intensity:
Fold change:
Significance:
-
C’ GFP library in SD

below threshold16.03 -
N' NOP1pr-GFP in SD

punctate,nucleus33.3019 -
N' TEF2pr-mCherry in SD

missing0 -
N' NATIVEpr-GFP in SD

punctate22.7161 -
N' TEF2pr-VC and Cyto-VN in SD

#N/A0 -
C’ GFP library in SD+DTT
cytosol19.611.22No -
C’ GFP library in SD+H2O2

cytosol16.041No -
C’ GFP library in Starvation Media

cytosol19.461.21No -
C’ GFP library on the background of Pup2-DaMP

below threshold -
C’ GFP library on the background of CCT mutant

below threshold17.25461.07567No
